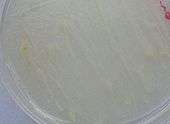

Mycobacterium abscessus
| Mycobacterium abscessus | |
|---|---|
| Scientific classification | |
| Kingdom: | Bacteria |
| Phylum: | Actinobacteria |
| Order: | Actinomycetales |
| Suborder: | Corynebacterineae |
| Family: | Mycobacteriaceae |
| Genus: | Mycobacterium |
| Species: | M. abscessus |
| Binomial name | |
| Mycobacterium abscessus Kusonoki and Ezaki 1992[1] | |
Mycobacterium abscessus is a rapidly growing mycobacterium that is a common water contaminant. It was until recently (1992) thought to be a subspecies of Mycobacterium chelonae. M. abscessus can cause chronic lung disease, post-traumatic wound infections, persistent culture-negative skin infections[2] and disseminated cutaneous diseases, mostly in patients with suppressed immune systems.
It is classified as a rapid growing mycobacterium.[3]
Description
M. abscessus cells are gram-positive, nonmotile, acid-fast rods of about 1.0 - 2.5 µm long by 0.5 µm wide. They may form colonies on Löwenstein-Jensen media that appear smooth or rough, white or greyish and nonphotochromogenic.
Physiology
M. abscessus shows growth at 28 °C and 37 °C after 7 days but not at 43 °C. It may grow on MacConkey agar at 28 °C and even 37 °C. It shows tolerance to saline media (5% NaCl) as well as 500 mg/l hydroxylamine (Ogawa egg medium) and 0.2% picrate (Sauton agar medium). Strains of the species have been shown to degrade the antibiotic p-aminosalicylate. M. abscessus has also been shown to produce arylsulfatase but not of nitrate reductase and Tween 80 hydrolase. It shows a negative result for the iron uptake test and no utilisation of fructose, glucose, oxalate or citrate as sole carbon sources.
Differential characteristics
M. abscessus and M. chelonae can be distinguished from M. fortuitum or M. peregrinum by their failure to reduce nitrate and to take up iron. Tolerance to 5% NaCl in Löwenstein-Jensen media, tolerance to 0.2% picrate in Sauton agar, and non-utilisation of citrate as a sole carbon source are characteristics that distinguish M. abscessus from M. chelonae. M. abscessus and M. chelonae sequevar I share an identical sequence in the 54-510 region of 16S rRNA, though both species can be differentiated by their hsp65, ITS or rpoB gene sequences.
Genetics
A draft genome sequence of M. abscessus subsp. bolletii BDT was completed in 2012.[4] More than 25 different strains of this subspecies, including pathogenic isolates, have had their genomes sequenced.[5]
Pathogenesis
M. abscessus may cause chronic lung disease, post-traumatic wound infections, and skin infections in immunodeficient patients.
It can be associated with persistent culture-negative skin infections on otherwise healthy individuals. Culture-negative refers to an inability to produce a colony on typical agar plates. These persistent cutaneous infections have been seen at acupuncture sites.[2]
It can be associated with middle ear infections (otitis media).[6]
Type strain
ATCC 19977 = CCUG 20993 = CIP 104536 = DSM 44196 = JCM 13569 = NCTC 13031
Etymology
From the Latin ab- (“away”) + cedere (“to go”), an abscess is named for the notion that humors leave the body through pus. Mycobacterium abscessus was first isolated from gluteal abscesses in a 62-year-old patient who had injured her knee as a child and had a disseminated infection 48 years later. The species M. bolletii, named after the late microbiologist and taxonomist Claude Bollet, was described in 2006. In current taxonomy, M. bolletii and M. massiliense (named for Massilia, the ancient Greek and Roman name for Marseille, where the organism was isolated) have been incorporated into M. abscessus subsp. bolletii.[7]
References
This article incorporates public domain text from the CDC as cited
- ↑ Kusunoki, S.; Ezaki, T.; et al. (1992). "Proposal of Mycobacterium peregrinum sp. nov., nom. rev., and elevation of Mycobacterium chelonae subsp. abscessus (Kubica et al.) to species status: Mycobacterium abscessus comb. nov". Int. J. Syst. Bacteriol. 42: 240–245. doi:10.1099/00207713-42-2-240. PMID 1581184.
- 1 2 Song, Joon Young; Sohn, Jang Wook; Jeong, Hye Won; Cheong, Hee Jin; Kim, Woo Joo; Kim, Min Ja (2006-01-13). "An outbreak of post-acupuncture cutaneous infection due to Mycobacterium abscessus". BMC Infectious Diseases. 6: 6. doi:10.1186/1471-2334-6-6. ISSN 1471-2334. PMC 1361796
 . PMID 16412228.
. PMID 16412228. - ↑ Esteban J, Ortiz-Pérez A (December 2009). "Current treatment of atypical mycobacteriosis". Expert Opin Pharmacother. 10 (17): 2787–99. doi:10.1517/14656560903369363. PMID 19929702.
- ↑ Choi, G.-E.; Cho, Y.-J.; Koh, W.-J.; Chun, J.; Cho, S.-N.; Shin, S. J. (24 April 2012). "Draft Genome Sequence of Mycobacterium abscessus subsp. bolletii BDT". Journal of Bacteriology. 194 (10): 2756–2757. doi:10.1128/JB.00354-12.
- ↑ Davidson, Rebecca M.; Hasan, Nabeeh A.; de Moura, Vinicius Calado Nogueira; Duarte, Rafael Silva; Jackson, Mary; Strong, Michael (December 2013). "Phylogenomics of Brazilian epidemic isolates of Mycobacterium abscessus subsp. bolletii reveals relationships of global outbreak strains". Infection, Genetics and Evolution. 20: 292–297. doi:10.1016/j.meegid.2013.09.012.
- ↑ Linmans JJ, Stokroos RJ, Linssen CF (September 2008). "Mycobacterium abscessus, an uncommon cause of chronic otitis media: a case report and literature review". Arch. Otolaryngol. Head Neck Surg. 134 (9): 1004–6. doi:10.1001/archotol.134.9.1004. PMID 18794448.
- ↑ Etymologia: Mycobacterium abscessus subsp. bolletii. Emerg Infect Dis [Internet]. 2014 Mar [February 20, 2014]. doi:10.3201/eid2003.ET2003